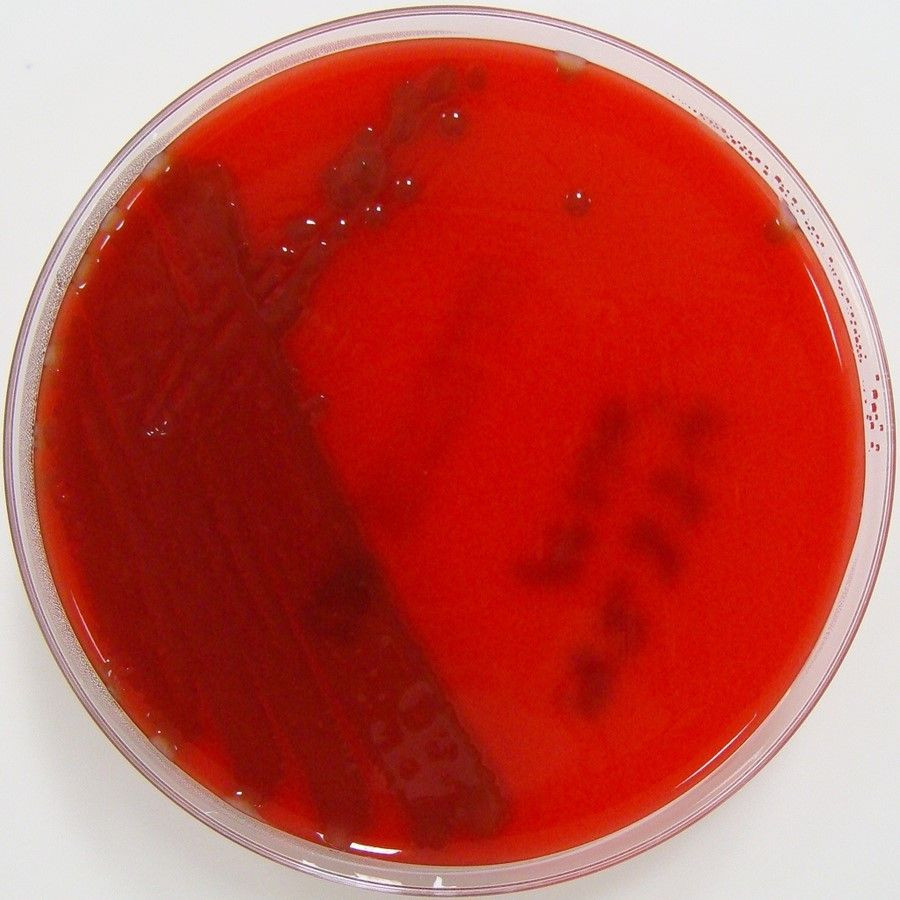

Las bacterias causantes de la meningitis pueden percibir la fiebre para evitar la eliminación inmunitaria
Investigadores del Instituto Karolinska de Suecia han descubierto un mecanismo por el que las bacterias que causan la meningitis pueden eludir nuestro sistema inmunitario. En pruebas de laboratorio, descubrieron que el `Streptococcus pneumoniae` y el `Haemophilus influenzae` responden al aumento de las temperaturas produciendo salvaguardas que evitan su muerte.
"Este descubrimiento ayuda a comprender mejor los mecanismos que utilizan estas bacterias para eludir nuestras defensas inmunitarias normales --afirma el coautor Edmund Loh, investigador del Departamento de Microbiología, Tumores y Biología Celular del Instituto Karolinska--. Podría ser una pieza importante del rompecabezas para examinar qué convierte a esta bacteria, normalmente inofensiva, en una asesina letal".
La meningitis es una inflamación de las membranas que rodean el cerebro y la médula espinal. Puede estar causada por virus, bacterias, hongos y parásitos.
La meningitis bacteriana es uno de los tipos más graves y una de las principales causas de muerte y discapacidad en niños de todo el mundo. Hay varios tipos de bacterias que pueden causar la infección, como los patógenos respiratorios \'Streptococcus pneumoniae\' y \'Haemophilus influenzae\', a los que se atribuyen unas 200.000 muertes anuales por meningitis.
Estas dos bacterias suelen residir en la nariz y la garganta de las personas sanas sin enfermar. En algunos casos se extienden al torrente sanguíneo y causan enfermedades invasivas, pero las razones de ello siguen siendo en gran medida desconocidas.
En este estudio, los investigadores se propusieron investigar la conexión entre los cambios de temperatura y la supervivencia de estas bacterias en un entorno de laboratorio. Los experimentos fueron impulsados por otro hallazgo reciente que relacionaba la capacidad de detección de la temperatura de la bacteria \'N. meningitidis\' con la enfermedad meningocócica invasiva.
Uno de los signos de una infección es la elevación de la temperatura y la fiebre, que suelen estimular la capacidad de nuestro sistema inmunitario para combatir la enfermedad. En este estudio, sin embargo, los investigadores descubrieron que tanto \'S. pneumoniae\' como \'H. influenzae\' activaban protecciones inmunitarias más fuertes cuando se les desafiaba con temperaturas más altas.
Lo hacían a través de mecanismos que implicaban a cuatro denominados termosensores de ARN (RNAT) específicos, que son moléculas de ARN no codificantes sensibles a la temperatura. Estos RNAT ayudaron a impulsar la producción de cápsulas protectoras más grandes y de proteínas de unión al Factor H inmunomodulador, que ayudan a proteger a estas bacterias de los ataques del sistema inmunitario.
"Nuestros resultados indican que estas RNAT que detectan la temperatura crean una capa adicional de protección que ayuda a las bacterias a colonizar su hábitat normal en la nariz y la garganta --afirma el primer autor del trabajo, Hannes Eichner, estudiante de doctorado del mismo departamento--. Curiosamente, vimos que estas RNAT no poseen ninguna similitud de secuencia, pero todas conservan la misma capacidad de termosensado, lo que indica que estas RNAT han evolucionado de forma independiente para percibir la misma señal de temperatura en la nasofaringe para evitar la muerte inmunitaria".
Se necesita más investigación para entender exactamente qué es lo que desencadena que estos patógenos pasen de la membrana mucosa al torrente sanguíneo y luego al cerebro. Los investigadores afirman que se necesitan estudios futuros que incluyan un modelo de infección in vivo para caracterizar el papel de estas RNAT durante la colonización y la invasión.




























Sé el primero en comentar